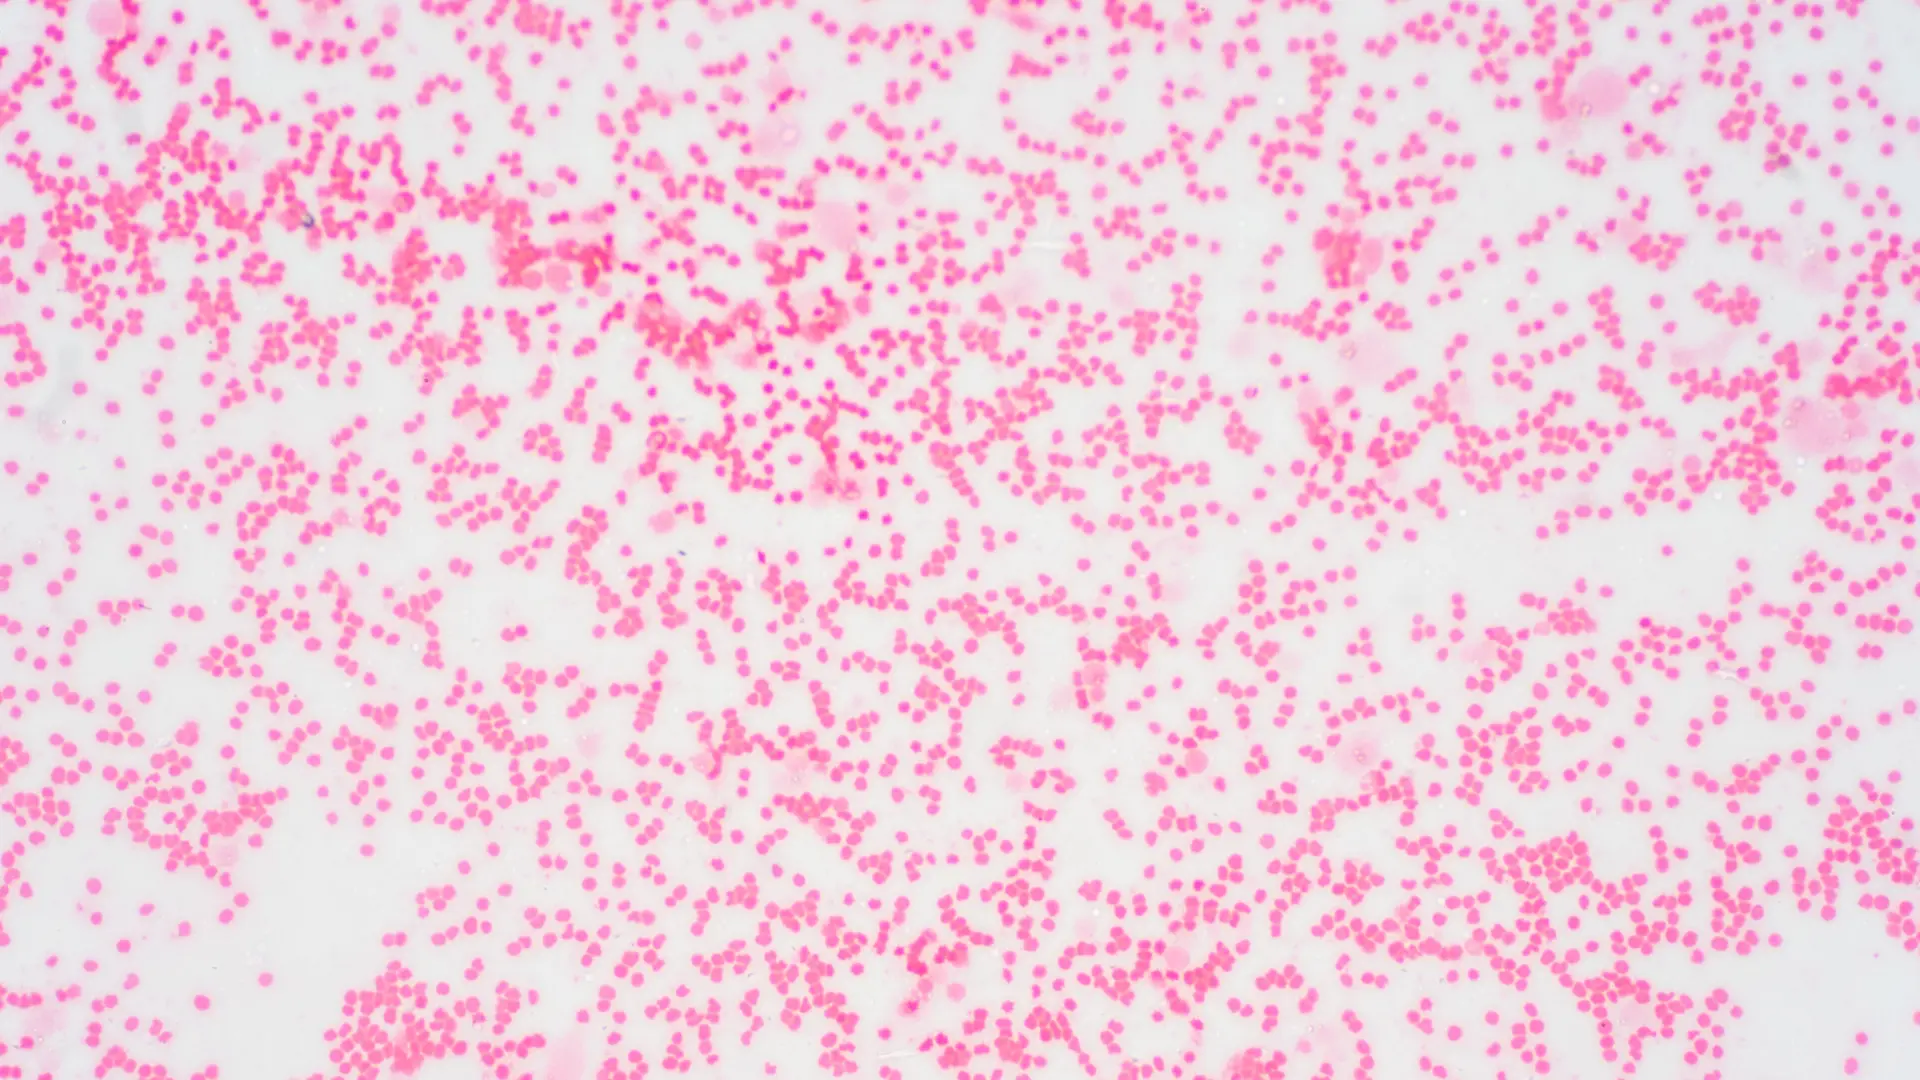
Wstępna diagnostyka chorób szpiku i chłoniaków w Krakowie

Diagnostyka Chorób Szpiku i Chłoniaków w Krakowie
Pierwszy krok w diagnostyce onkohematologicznej. Profesjonalna konsultacja niepokojących objawów i wyników.
Niepokojące Objawy? Nie Czekaj. Zacznij od Rzetelnej Diagnostyki.
Podejrzenie choroby nowotworowej krwi, takiej jak białaczka, chłoniak czy zespół mielodysplastyczny (MDS), budzi ogromny lęk. W takiej sytuacji kluczowe jest szybkie działanie i trafienie pod opiekę doświadczonego specjalisty. W CM Femmemedica rozumiemy Twoje obawy.
Naszą rolą jest zapewnienie Ci szybkiej, profesjonalnej diagnostyki wstępnej, która pozwoli potwierdzić lub wykluczyć podejrzenia i w razie potrzeby, bezzwłocznie pokierować Cię na dalsze leczenie.
Sygnały Alarmowe, Których Nie Można Ignorować
Znaczący spadek masy ciała bez zmiany diety lub aktywności fizycznej.
Obfite, zlewne poty w nocy, wymagające zmiany pościeli lub bielizny.
Głębokie zmęczenie, które nie ustępuje po odpoczynku i utrudnia codzienne funkcjonowanie.
Niebolesne, twarde, powiększone węzły chłonne (szyi, pach, pachwin), które nie znikają.
Nawracające infekcje i gorączki, które mogą świadczyć o osłabieniu odporności.
Tępe, uporczywe bóle kości, zwłaszcza w okolicy mostka, żeber czy miednicy.
Nasz Proces Diagnostyczny Krok po Kroku
Krok 1: Konsultacja i Wywiad
Pierwszym i najważniejszym krokiem jest szczegółowa rozmowa z naszym hematologiem na temat Twoich objawów i historii zdrowia.
Krok 2: Badania z Krwi
Na podstawie wywiadu lekarz zleci celowane badania krwi, w tym morfologię z rozmazem i inne specjalistyczne markery.
Krok 3: Badania Obrazowe
W razie potrzeby, w naszej placówce wykonasz USG jamy brzusznej w celu oceny śledziony, wątroby i węzłów chłonnych.
Krok 4: Skierowanie i Plan
Jeśli wstępna diagnostyka wskaże na konieczność dalszych badań (np. biopsji szpiku), otrzymasz skierowanie do specjalistycznego ośrodka i jasny plan dalszego postępowania.
Twoje Wsparcie w Procesie Diagnostyki

dr n. med. Barbara Grabowska
hematolog oraz ultrasonografista od USG piersi, brzucha i tarczycy
Dr n. med. Barbara Grabowska posiada ponad 20-letnie doświadczenie zdobyte na oddziale hematologii, co daje jej unikalną perspektywę w diagnozowaniu najpoważniejszych schorzeń krwi. Jej empatia i profesjonalizm zapewniają pacjentom wsparcie w trudnym procesie diagnostycznym.
Ważne Pytania i Odpowiedzi (FAQ)
Czy CM Femmemedica leczy białaczkę i chłoniaki?
Czy w CM Femmemedica wykonuje się biopsję szpiku kostnego?
Mam powiększony węzeł chłonny. Czy to rak?
Nie Zostawaj z Wątpliwościami Sam/a
Jeśli Twoje objawy lub wyniki badań budzą niepokój, szybka konsultacja z doświadczonym hematologiem to najważniejszy krok. Umów wizytę w CM Femmemedica w Krakowie.
